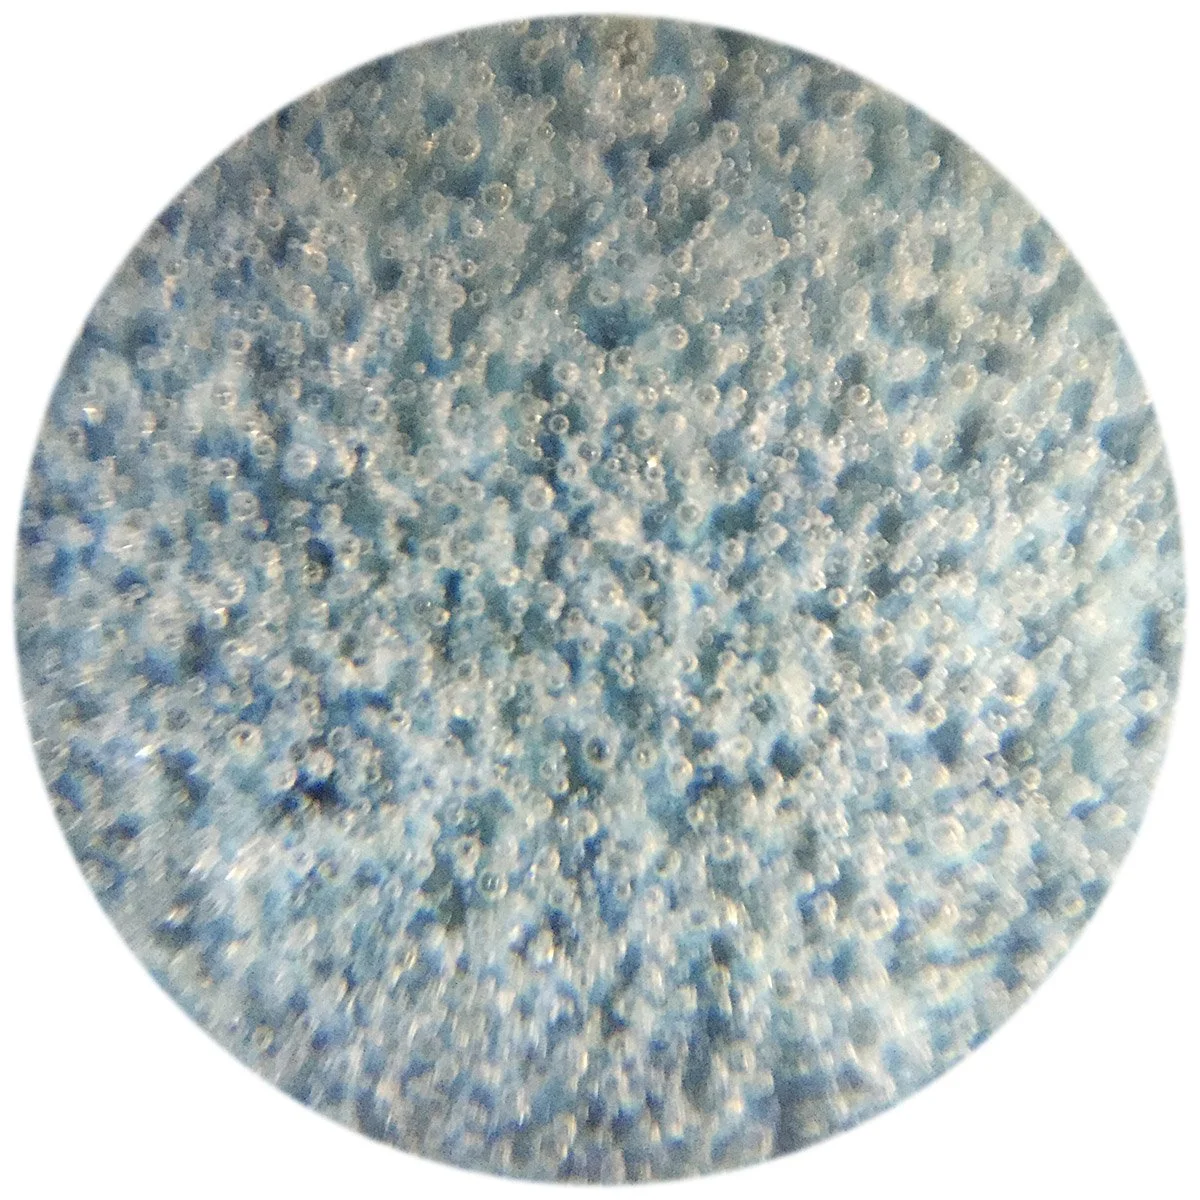

Smartphone Microscopy
Last year I purchased a USB microscope (see article). It's pretty fun, but ultimately I was really disappointed by the quality of the images. The 5MP sensor seems pretty cheap and images have a lot of artifacts. Furthermore I was never satisfied with the color.
The best choice would probably be a "real" microscope with a camera adapter. However, this little hobby of mine doesn't justify spending a lot of cash.
There are a few tutorials online for creating your own phone microscope using the lens of a laser pointer. (I tried this and it worked pretty well, but I never found a way to conveniently attach the lens to the camera.) Wired's article Turn Your Cellphone Into a High-Powered Scientific Microscope has a good tutorial as well as background on the scientists who are using cellphones as biomedical devices.
Fortunately there are now multiple products for sale that make it easier to attach a lens to the phone.
There's a former Kickstarter project that looks promising and is shipping, the 15x Micro Phone Lens and 150x Micro Phone Lens. (See my November 2016 update, below.) In China there are a number of cheap alternatives.
Supereyes Smartphone Microscope (Not recommended)
I purchased the Supereyes Smartphone Microscope for about $7USD. The images below were taken with this lens. Unfortunately the top of the plastic lens is not protected and I scratched it after playing with it for less than an hour.
The images from the iPhone with attached lens look much better than my USB microscope. The photos below were taken in natural light.
The lens attached to the iPhone. On top is a plastic cover which is easily scratched. I removed it with a Dremel.
View of ruler through attached iPhone lens
View of ruler through attached iPhone lens
Qing Dynasty Guan glaze
Qing Dynasty Guan glaze
A Wanli dish shard
Blue & White birds in the Wanli shard
Teadust Glaze
Iron Red (Kaki) Glaze
A celadon glaze I'm working on
Eyeskey 12x Micro Lens
It was only after using the Supereyes lens that I realized it’s horrible design (does not fit on camera lens, slides off the camera lens, plastic cover easily scratched, etc.) that I bought another cheap microscope lens, the Eyeskey 12x Micro Lens (also about $7USD).
The Eyeskey model is designed much better. An adapter slides perfectly over the phone and the lens is screwed into the adapter. The plastic tube that is visible using the Supereyes lens is not a problem here. The magnification is also greater than the Supereyes lens.
(Unfortunately I could not find this model for sale in the West. However, I think the 15x Micro Phone Lens might be even better.)
The Eyeskey lens with phone adapter. Much better design than the Supereyes.
Viewed using the Eyeskey lens. Notice that there is no circular tube visible.
Zooming in with fingers (digital zoom). Magnification is higher than the Supereyes model.
Another Iron Red glaze
Strange rivulets and eyes in a Tenmoku glaze containing Rice Straw Ash
A Jun celadon glaze on black stoneware
Porcelain stone and wood ash with carbon trapping and iron spots
Coleman Kaki on porcelain, cone 9
Comparison of Supereyes and Eyeskey Lenses
Supereyes lens
Supereyes lens digital zoom
Eyeskey lens
Supereyes lens digital zoom
Microphonelens 8x Macro & 15x Micro Lens
On a recent trip to the US I ordered the Microphonelens 8x Macro lens and 15x Micro lens. These lenses are different than others- they simply stick to the phone’s camera lens and have no outer support column.
In use, I found it more difficult than the other lenses because I could not directly rest the lens at the correct distance against the viewed object, resulting in more blurry photos due to camera shake. Also, while the micro lens is designed to stick on the phone lens it falls off if touched and gets dirty in the process of handling.
These drawbacks are forgivable, though, as the quality of the images seems superior to either of the other lenses I tested. Also, the lens cleans up easily with just a bit of pure or soapy water. The soft material also scratches less easily than hard plastic lenses.
For viewing glazes, both the 8x and 15x lenses are useful. I would recommend the 15x (although of course it has a narrower depth of field).
The microphonelens case with lenses
The 15x microphonelens lens on an iPhone
8x microphonelens macro lens
8x microphonelens macro lens
15x microphonelens micro lens
15x microphonelens micro lens
Blurred image, lens just needs cleaning in a bit of water.
Stitching photos
I tried the iPhone’s panorama feature but it did not work. The iPhone panorama gets confused. However, you can take multiple photos (moving the camera slightly each shot) and then stitch the photos together using software. Adobe Lightroom (Photo Merge->Panorama) and Photoshop (Automate->Photomerge) have this feature , however it takes a lot of time and seems limited to 100 or so photos. I tried a free program called AutoStitch that worked pretty well.
AutoStitch image stitch of Iron Red (Kaki) glaze. Autostitch options: Multiband->Blending Bands = 2 (default). You can see a lot of ghosting where images weren't aligned properly. Photos from Supereyes lens.
AutoStitch image stitch of Iron Red (Kaki) glaze. Autostitch options: Multiband->Blending Bands = 10 (needed over an hour to process 78 photos). Photos from Eyeskey lens.
AutoStitch image stitch of crazy Tenmoku iron glaze by Kimura Moriyasu. Photos from Eyeskey lens.
Photoshop photo merge of Song dynasty saggar with natural wood ashes. Photos from Eyeskey lens. Photoshop seems to do a better job than AutoStitch (in default mode).